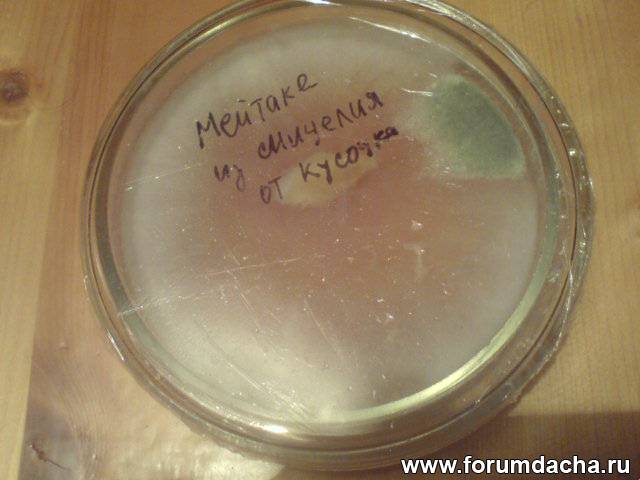

|

| Автор |
Сообщение |
А.Ю. |
|
|
Зарегистрирован: 02.05.2011
Сообщения: 182
Откуда: Москва
|

|
25-10-2012, 08:07 |
 Заголовок сообщения: |
| Александр Дворянинов писал(а): |
| А.Ю. писал(а): |
| Еще раз уточняю, если мицелий дал конкурент, то цвет должен поменяться с чисто белого на какой-либо оттенок, да? |
Необязательно. |
 Мдаааа..... Мдаааа.....
Получается, что можно вырастить, а увидишь что вырастил только когда получишь плодовое тело? Или не получишь....
Видимо При любом раскладе придется мне сажать в землю и то что сам вырастил, и для надежности то, что вырастите вы. Так что мой заказ ВСЕХ веселок у вас остается в силе. Посажу в разных местах и буду наблюдать.
|
|
А.Ю. |
|
|
Зарегистрирован: 02.05.2011
Сообщения: 182
Откуда: Москва
|

|
25-10-2012, 09:17 |
 Заголовок сообщения: |
Вот так выглядит разросшийся мицелий из пересаженного первичного мицелия Веселки обыкновенной, полученного из спор

А вот так (на фото ниже) выглядит мицелий Мейтаке выросшего из кусочка гриба..
Непосредственно рядом с кусочком, мицелий низкой плотности, что как бы создает на фото иллюзию его отсутствия (на самом деле он есть), а к краю банки он более густой. Из чего я делаю вывод, что он рос линейно и радиально направленно, но бортик банки ограничил его продвижение, поэтому продолжая расти, у края его стало больше и он стал более заметен.
Вырезанная часть - место поражения конкурентом.

Еще ниже на фото результат пересадки мицелия мейтаке на кусочке агара ( с того что на предущем фото). На нем наблюдается точно такая же картина радиального роста и наибольшая концентрация плотности в месте ограничения продвижения. Особенно эаметно направление роста в месте поражения мицелия конкурентом. Зеленый окрас участка поражения выделяет сектор, а края сектора подчеркивают направление и начало роста от кусочка агара. .
Конкурента я занес видимо на кусочке агара, поскольку взял его рядом с вырезанной зараженной частью. И это не смотря на то, что визуально это место уже было чисто от конкурента.

Аналогичную картину роста мицелия из кусочка плодового тела дала Веселка обыкновенная. Это пересаженный кусочек на агаре на новую среду. Картинка роста мицеля аналогична росту мицелия от кусочка Мейтаке . Никакого войлчного мицелия, как при росте из спор. (фото ниже)

|
|
Александр Дворянинов |
|
|
Зарегистрирован: 30.05.2012
Сообщения: 482
|

|
25-10-2012, 09:38 |
 Заголовок сообщения: |
| А.Ю. писал(а): |
| Мдаааа.....Получается, что можно вырастить, а увидишь что вырастил только когда получишь плодовое тело? Или не получишь.... Видимо При любом раскладе придется мне сажать в землю и то что сам вырастил, и для надежности то, что вырастите вы. |
Гарантировать на 100% можно только культуру полученную из плодового тела .... или из спор, но сходный по морфологическим признакам мицелий, а вдобавок и проверенный выращиванием.
|
|
Александр Дворянинов |
|
|
Зарегистрирован: 30.05.2012
Сообщения: 482
|

|
25-10-2012, 09:44 |
 Заголовок сообщения: |
Я я не вижу мицелия Весёлки и Майтаке на чашках петри. Мицелий майтаке может и есть, но с примесью конкурента, захватившего всё пространство.
Последний раз редактировалось: Александр Дворянинов (28-01-2013, 07:06), всего редактировалось 2 раз(а)
|
|
А.Ю. |
|
|
Зарегистрирован: 02.05.2011
Сообщения: 182
Откуда: Москва
|

|
25-10-2012, 11:14 |
 Заголовок сообщения: |
| Александр Дворянинов писал(а): |
| Я я не вижу мицелия Весёлки и Майтаке на чашках петри. мицелий майтаке может и несть, но с примесью конкурента, захватившего всё пространство. |
Вы наверное подумали, что пух начал расти от края? Я писал, что на фотографии мицелий идущий от кусочка не виден, глазом виден. То есть, мицелий у краев - он вырос от центра. В начале роста, когда он постепенно увеличивался, это было особенно видно. Он постепенно лучиками от центра расходился к краям и потом у краев стал уплотняться. И так произошло и в случае с кусочком и в случае когда я пересадил кусочек обжитого агара. Все в точности повторилось. Кусочек агара с пухом мицелия стал давать радиальные постепенно расширяющиеся лучи мицелия (или то, что вы называете не мицелием). Дойдя до преграды он стал кучковаться в более заметное глазу образование.
Ладно, посмотрю что летом даст в почве. И надеюсь вы сообщите когда у вас будет материал для посадки.
|
|
А.Ю. |
|
|
Зарегистрирован: 02.05.2011
Сообщения: 182
Откуда: Москва
|

|
21-11-2012, 12:47 |
 Заголовок сообщения: |
Итак, изо всех присланных спор удалось получить мицелий на агаре. Нашел удачную консистенцию для агаровой среды. Последним положительным результатом стал мицелий их присланных спор Веселки Хрящеватой от Александра Ивановича. Долго я за эти споры не брался после неудачного первого результата.
Веселка Хрящеватая с небольшими вкраплениями чужих. Скорее всего Веселка их съест. Не съест так вырежу или пересажу Веселку.
 |
Имя файла: DSC00394.JPG
Размер файла: 55,21 KB
Скачано: 177 раз(а)
|
|
|
kov314 |
|
|
Зарегистрирован: 16.08.2012
Сообщения: 28
|

|
27-01-2013, 19:43 |
 Заголовок сообщения: |
СКОЛЬКО МНОГО ГОВОРИТСЯ О МИЦЕЛИИ ВЕСЕЛКИ , А РЕАЛЬНО У КОГО НИБУДЬ ЕСТЬ МИЦЕЛИЙ ВЕСЕЛКИ ? javascript:emoticon('  ')
|
|
А.Ю. |
|
|
Зарегистрирован: 02.05.2011
Сообщения: 182
Откуда: Москва
|

|
28-01-2013, 01:38 |
 Заголовок сообщения: |
Что касается моих опытов, то то что у меня выросло может быть подтверждено только экспериментом на почве, Поскольку Александр Дворянинов ( а он практикующий специалист) выше каментами весьма не лестно отозвался о плодах моих экспериментов, уверенности, что вырос именно мицелий у меня нет. Хотя надежда остается.
|
|
Александр Дворянинов |
|
|
Зарегистрирован: 30.05.2012
Сообщения: 482
|

|
28-01-2013, 06:51 |
 Заголовок сообщения: |
| А.Ю. писал(а): |
| Что касается моих опытов, то то что у меня выросло может быть подтверждено только экспериментом на почве, Поскольку Александр Дворянинов ( а он практикующий специалист) выше каментами весьма не лестно отозвался о плодах моих экспериментов, уверенности, что вырос именно мицелий у меня нет. Хотя надежда остается. |
По внешним признакам, мицелий Весёлки имеет другой внешний вид, отличающийся от вида, на Вашем фото. Даже по внешним признакам могу утверждать, что это не мицелий весёлки. Надежда как всегда, умирает последней.
|
|
kov314 |
|
|
Зарегистрирован: 16.08.2012
Сообщения: 28
|

|
28-01-2013, 18:20 |
 Заголовок сообщения: |
ЭТО
Последний раз редактировалось: kov314 (01-02-2013, 20:30), всего редактировалось 2 раз(а)
|
|
Александр Кузнецов |
|
|
Зарегистрирован: 23.10.2009
Сообщения: 6770
Откуда: Алтайский край, р.ц.Алтайское
|

|
28-01-2013, 18:22 |
 Заголовок сообщения: |
За Ваши деньги всё возможно! 
Только речь то в теме о другом: об активном мицелии для засева в сад! 
В смысле успех дела определяет не количество а качество..
|
|
Александр Дворянинов |
|
|
Зарегистрирован: 30.05.2012
Сообщения: 482
|

|
01-03-2013, 21:30 |
 Заголовок сообщения: |
Хочу пояснить ситуацию с мицелием Весёлки обыкновенной. В стерильных условиях, мицелий той культуры что получил из плодового тела, растёт очень медленно, как на лигно среде, так и на чашках петри.

 В банках, на приведённой фотографии, рост культуры с момента введения. Высевалась культура из чашек петри на зерно, такая же история и на зерне. В чём может быть причина замедленного роста? Предполагаю (из наблюдений за культурой на нестерильных средах) что культура в стерильных условиях не имеет контакта с конкурентным мицелием, который Весёлка использует для своего быстрого развития. В нестерильных условиях мицелий Весёлки трансформируется из воздушного мицелия, в гифовые формы мицелия и эффективно захватывает субстрат, именно гифами. И видимо использует мицелий конкурентов для быстрого своего развития. Это моё предположение, основано из фактических наблюдений, за развитием мицелия Весёлки на нестерильных сосновых опилках. Высевая споры Весёлки хрящеватой на чашке петри, однажды когда среда покрылось спорами Аспергилла, отложил её на выкид, но забыл это сделать, и вспомнил про неё только через 2 недели. Какое же было моё удивление, на поверхности спор Аспергилла торчали тифы Весёлки хрящеватой. Думал сейчас отделю кусочек гифы и перенесу на другую чашку, но попытки выделить вегетативную форму Весёлки хрящеватой не удалось, развивался только Аспергилл, к каким только ухищрения не прибегал, безрезультатно. Пробовал выделить чистую культуру и с сосновых опилок, результат тот же. Сложилось мнение что когда мицелий Вселки столкнулся с любым конкурентным мицелием, она срастается с ним и начинает использовать его для своего развития, и разделить этот союз не получается никакими методами. На фотографиях, в чашках петри мицелий рос почти два месяца. Хочу сказать, что до массовой рассылки мицелия Весёлки, придётся подождать, нужно ещё время для выяснения всех обстоятельств, и поиска возможных решений. С уважением, Александр Дворянинов.
P.S.
Может кто из коллег подскажет возможное решение данной ситуации!
|
|
Александр Кузнецов |
|
|
Зарегистрирован: 23.10.2009
Сообщения: 6770
Откуда: Алтайский край, р.ц.Алтайское
|

|
01-03-2013, 21:57 |
 Заголовок сообщения: |
Одно из возможных решений- это изменение состава субстрата. Учитывая тот факт, что Весёлка обыкновенная всё же больше гумусовый сапротроф, чем подстилочный... Возможно поэтому использует другие грибы для своего пропитания на средах менее питательных для этого вида.
|
|
Александр Дворянинов |
|
|
Зарегистрирован: 30.05.2012
Сообщения: 482
|

|
02-03-2013, 08:33 |
 Заголовок сообщения: |
Буду испытывать разные составы субстратов. Спасибо.
|
|
bbcom |
|
|
Зарегистрирован: 11.02.2013
Сообщения: 221
Откуда: МО
|

|
02-03-2013, 09:37 |
 Заголовок сообщения: |
А что с температурой? ЧП отложенная на выкид и остальные культуры находились в одинаковых условиях? Если t одинаковая, то дело скорее всего в субстрате. Что за зерно использовалось? Попробуйте рожь, или пшеницу, уж на них по-моему, растет все, что угодно.  Так же, возможно стоит заменить сосновые опилки на опилки лиственных пород деревьев, все-таки сосна не самый лучший вариант т.к. в ней содержатся смолы.
И еще заметил, что в банках у Вас довольно влажно - заметны капельки конденсата и мицелий не осваивает нижнюю часть субстрата, (как раз, где могут скапливаться излишки влаги).
|
|
Александр Дворянинов |
|
|
Зарегистрирован: 30.05.2012
Сообщения: 482
|

|
02-03-2013, 12:42 |
 Заголовок сообщения: |
Температура стабильная +23*С. Пробовал разные субстраты, из зерна, не пробовал рожь и горох, попробую, Составлял разные композиции по питанию, результат один, медленный рост. В том то и дело что в нестерильных условия прёт и по сосновым опилкам, только в гифовой форме. В банках верхний слой уже высох и от сухости сжался, в нижней части банки мицелий весёлки просто ещё не дорос, он осваивает только очень медленно, и может через месяц освоит и самый низ банки. На зерне развивается мицелий, но тоже очень медленно, после двух месяцев зерно подсыхает, и мицелий прекращает рост полностью, а мицелий осваивает за это время площадь с грецкий орех. Со спорами первое время что только не пробовал и ферменты и органические кислоты, а ларец открывался просто, нужна была обычная вода для инъекций, не более того, и всё встало на свои места, С Весёлкой работаю впервые, и у каждой культуры есть свои особенности, которые требуют изучения, и для этого нужно время, а нам хочется всё и сейчас. Но не всегда коту пирог, бывает и мордой о п..... .Спасибо за участие!
|
|
bbcom |
|
|
Зарегистрирован: 11.02.2013
Сообщения: 221
Откуда: МО
|

|
02-03-2013, 14:00 |
 Заголовок сообщения: |
| Александр Дворянинов писал(а): |
| а ларец открывался просто, нужна была обычная вода для инъекций, не более того |
Интересно! Вода для инъекций - это бидистиллированная вода, но думаю, подошел бы и обычный дистиллят.
Попробуйте тогда отварить зерно в дистиллированной воде. Не бывает такого, чтобы мицелий не рос на зерне. И если зерно используется без каких-либо добавок, то причину искать вроде как больше и негде. 
|
|
Александр Дворянинов |
|
|
Зарегистрирован: 30.05.2012
Сообщения: 482
|

|
02-03-2013, 15:30 |
 Заголовок сообщения: |
Добавки все исключу. Вот и я голову уже сломал!
|
|
Юрий Р |
|
|
Зарегистрирован: 02.03.2013
Сообщения: 27
Откуда: Ростовская область
|

|
02-03-2013, 20:32 |
 Заголовок сообщения: |
| Александр Дворянинов писал(а): |
| А.Ю. писал(а): |
| Мдаааа.....Получается, что можно вырастить, а увидишь что вырастил только когда получишь плодовое тело? Или не получишь.... Видимо При любом раскладе придется мне сажать в землю и то что сам вырастил, и для надежности то, что вырастите вы. |
Гарантировать на 100% можно только культуру полученную из плодового тела .... или из спор, но сходный по морфологическим признакам мицелий, а вдобавок и проверенный выращиванием. |
К слову о гарантированном определении культуры - достаточно быстро, за пару-тройку дней, можно узнать, кто у вас разросся, можно молекулярными методами. Секвенирование (распознавание последовательности нуклеотидов в определенном участке ДНК) хоть и достаточно накладно (около 2-2,5 тысяч р), но результат надежный.
|
|
Александр Дворянинов |
|
|
Зарегистрирован: 30.05.2012
Сообщения: 482
|

|
02-03-2013, 21:47 |
 Заголовок сообщения: |
Да согласен. Можно определить ещё электрофоретическим способом, но нужны плодовые тела. Институт генетики у нас есть в Воронеже. Но не вижу смысла, за эти же деньги можно заказать культуру в Институте ботаники, и не одну. И быть уверенным в её соответствии. Здесь в чём заинтересованность, собрать разновидности Весёлки из разных таксономических групп, объединённых общими свойствами и признаками, да и не только Весёлки.
|
|
|
|
|
|
|
 |
|
Вы не можете начинать темы
Вы не можете отвечать на сообщения
Вы не можете редактировать свои сообщения
Вы не можете удалять свои сообщения
Вы не можете голосовать в опросах
Вы не можете вкладывать файлы
Вы можете скачивать файлы
|
|
|
 Мдаааа.....
Мдаааа.....

')
')




 Так же, возможно стоит заменить сосновые опилки на опилки лиственных пород деревьев, все-таки сосна не самый лучший вариант т.к. в ней содержатся смолы.
Так же, возможно стоит заменить сосновые опилки на опилки лиственных пород деревьев, все-таки сосна не самый лучший вариант т.к. в ней содержатся смолы.
